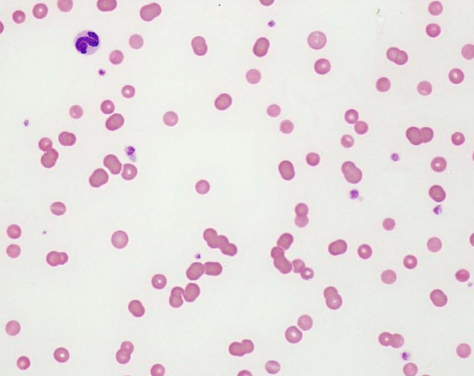
<p>anemia of chronic disease</p>
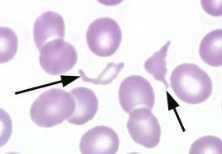
<p>-intravascular hemolysis</p><p>-endothelial damage and/or fibrin deposition</p><p>-secondary hemolysis</p><p>-+/- schistocytes</p>

Oncology 10 (paraneoplastic syndromes)
1/59
There's no tags or description
Looks like no tags are added yet.
Name | Mastery | Learn | Test | Matching | Spaced |
|---|
No study sessions yet.
60 Terms
what are paraneoplastic syndromes (PNS)?
disease or symptom that is a consequence of neoplasia but occurs distant from the tumor
unrelated to physical actions of tumor
what do PNSs result from?
result from production and release of substances not normally produced by the tumor cell of origin or that are not normally produced in extreme amounts
what types of substances can cause PNSs?
hormones
cytokines
peptides
growth factors
what is the clinical significance of PNSs?
PNSs are often the first sign of malignancy and may be hallmarks of certain cancers
in most cases, PNS parallels underlying malignancy

True or False? PNSs may result in greater morbidity than the tumor itself
true

True or False? Hematologic PNS such as anemia is rarely seen.
False. Anemia is a very common PNS

what are the mechanisms of anemia?
1. hemorrhage (internal or external)
2. hemolysis (extravascular or intravascular)
3. decreased bone marrow production (intramedullary or extramedullary)

what are the major mechanisms of PNS anemia?
1. anemia of chronic disease
2. blood loss
3. IMHA
4. microangiopathic hemolytic anemiaa

what is the most common cause of anemia in cancer patients?
anemia of chronic disease
what type of anemia is seen in anemia of chronic disease (PNS)?
normocytic, normochromic, non-regenerative anemia (often mild- PCV 32-37%)
due to decreased bone marrow production

what is the etiology of anemia of chronic disease (PNS)?
-defects in iron storage and metabolism
-shortened RBC span
- +/- decreased bone marrow response

what is the treatment of choice for PNS anemia of chronic disease in cancer patients?
remove/treat tumor, and monitor

what is the etiology of immune mediated hemolytic anemia (PNS IMHA)?
-extravascular hemolysis (liver, spleen, bone marrow)
-self-antibodies against RBCs
--> RBCs tagged for destruction

how is IMHA diagnosed?
-regenerative anemia
-hyperbilirubinemia
-spherocytes
-saline agglutination
- +/- coombs' positive

what is the treatment for IMHA (PNS)?
-removal/treatment of tumor
-immune suppression

what is the etiology of PNS anemia caused by blood loss?
-bleeding tumors
-mostly due to hemangiosarcoma (but also many other tumor types)

how is PNS anemia caused by blood loss diagnosed?
-regenerative anemia
-cause may be obvious (external) or hidden (internal)

how is microangiopathic hemolytic anemia diagnosed?
-intravascular hemolysis
-endothelial damage and/or fibrin deposition
-secondary hemolysis
-+/- schistocytes
what are causes of microangiopathic hemolytic anemia (PNS)?
-hemangiosarcoma
-PNS disseminated intravascular coagulation (DIC)

what are the mechanisms of PNS thrombocytopenia?
-increased destruction
-decreased production
-consumption
-sequestration
secondary IMTP possible

what are causes of PNS thrombocytopenia?
-neoplasia infiltrating bone marrow (lymphoproliferative)
-vascular tumors of the spleen

how is PNS thrombocytopenia treated?
-removal/treatment of tumor
-immunosuppression if IMTP

what is the most common cause of hypercalcemia in dogs?
cancer (60% of cases)
how common is it for cats with neoplasia to get hypercalcemia?
30% of cats diagnosed with neoplasia have hypercalcemia
what are the most common tumors causing hypercalcemia of malignancy (HM)?
1. lymphoma
2. AGASACA
3. multiple myeloma
4. thymoma
5. thyroid carcinoma
many others
__ % of canine cases of lymphoma have hypercalcemia. __ % of AGASACA cases have hypercalcemia. And __ % of multiple myeloma cases have hypercalcemia.
10-35% of lymphoma
>25% of AGASACA
20% of multiple myleoma
what are mechanisms of hypercalcemia of malignancy?
1. tumor production of PTH or PTHrp
2. tumor production of proteins acting on osteoblasts or osteoclasts (stimulate bone resorption and increased calcium)
3. tumor induced production of vitamin D
4. direct tumor lysis of bone (extensive and usually multifocal lesions)

what are the renal-associated clinical manifestations of hypercalcemia of malignancy?
most effects are reversible:
-inability to concentrate urine
-decreased renal blood flow and GFR
-calcium deposition
-PU/PD

what are other clinical manifestations of hypercalcemia of malignancy?
-vomiting, constipation
-anorexia
-lethargy, weakness, depression
-bradycardia
-possible coma/death

what is the main goal of treating hypercalcemia of malignancy?
elimination of inciting tumor
what is the treatment for mild hypercalcemia of malignancy?
rehydration with normal saline

what is the treatment for moderate hypercalcemia of malignancy?
-rehydration, then diuresis with saline
-furosemide
-prednisone (only after confirmed diagnosis)

what is the treatment for severe hypercalcemia of malignancy?
emergency situation:
-start with rehydration, then furosemide
-bisphosphonates
-calcitonin

what is cachexia?
weight loss and metabolic alterations despite adequate nutritional intake
cachexia is a protein-calorie malnutrition (rare in vetmed cancer patients)
what is anorexia?
alterations resulting from poor nutritional intake
--> decreased food intake is common in our cancer patients
what is anorexia in veterinary cancer patients related to?
either to the cancer or treatments administered
what does excessive cytokine stimulation lead to?
insulin resistance and excessive fat and protein breakdown
what are causes of anorexia in veterinary cancer patients?
-increased inflammatory cytokines (IL-1 and IL-6) lead to hypothalamic suppression of appetite
-gastroduodenal ulceration (MCTs, gastrinomas)
-pain/obstruction caused by GI tumors
-chemotherapy

how can chemotherapy cause anorexia in veterinary cancer patients?
chemo can change smell and taste sensation which can decrease palatability of foods
can last for several months
what is hypertrophic osteopathy (HO)?
periosteal proliferation of new bone along shafts of long bones associated with malignant and non-malignant diseases

how/where does hypertrophic osteopathy appear on rads?
symmetrical periosteal new bone formation, nodular or speculated
classically radiating 90degrees from long axis

what is the etiology of hypertrophic osteopathy?
mostly unknown:
-tumor-induced production of growth factors/hormones
-increased periosteal blood flow
-afferent neurologic stimulation

what are the clinical signs of hypertrophic osteopathy?
-shifting leg lameness
-warm, swollen limbs
-reluctance to move
-can have rib or pelvis involvement
-1/3 may present with cough
-2/3 may present with ocular signs (discharge, episcleral injection)

what are neoplastic causes of hypertrophic osteopathy?
-pulmonary metastasis (esp OSA)
-primary pulmonary tumors
-renal, bladder tumors
-other abdominal tumors
what are non-neoplastic causes of hypertrophic osteopathy?
-heartworm disease
-heart disease
-pneumonia
-pregnancy
-granulomatous disease

what is the treatment for hypertrophic osteopathy?
treat underlying cause if possible
-primary lung tumor resection or metastasectomy (rapid resolution of symptoms)

what symptomatic therapy is used to manage hypertrophic osteopathy?
-prednisone or NSAIDs
-oral analgesics
-bisphosphonates
-palliative radiation

what are causes of fevers?
-infection
-inflammation
-autoimmune disease
-drug/blood products
-cancer (an important differential)

what is the pathogenesis of PNS fevers?
pathogenesis is associated with excess production of cytokines (IL-1, IL-6, TNF-a, interferons) and prostaglandins (PGE2)
may have a fever when tumor is secondarily infected

what is hypoglycemia?
blood glucose <60-70mg/dL
what are non-neoplastic differentials of hypoglycemia?
-lab error (rule out first)
-addison's disease
-hepatic disorders
-sepsis
-starvation (usually prolonged)
-toxicity
what is the most common neoplastic cause of hypoglycemia?
insulinomas in dogs (rare in cats): beta-islet cell tumors

what are other neoplastic causes of hypoglycemia (extra-pancreatic tumors)?
-hepatocellular carcinoma
-leiomyosarcoma/leiomyoma
-lymphoma
-plasma cell tumors
-mammary tumors

how is PNS hypoglycemia diagnosed with insulin-producing tumors?
low BG paired with high insulin level
-abdominal imaging (U/S and/or CT); usually too small to visualize
-abdominal explore
how is PNS hypoglycemia diagnosed with non-insulin producing tumors?
insulin levels may be low, normal or high
-usually large enough to locate on imaging (CT and/or U/S)
what is the treatment for PNS hypoglycemia?
depends on inciting tumor
-acute and chronic management of low blood glucose
-IV dextrose
-surgical resection
-small, frequent feedings
-prednisone (stimulates glucose production)
how common are cutaneous PNSs in veterinary cancer patients?
relatively uncommon

which animals is cutaneous PNS mostly seen in?
alopecia in cats with pancreatic or hepatobiliary carcinoma (acute onset, bilaterally symmetrical, shiny/glistening skin)

what is nodular dermatofibrosis?
inherited mutation leading to overproduction of folliculin--> forms dense nodules of collagen

which animals is nodular dermatofibrosis seen in?
german shepherds
-autosomal dominant inheritance (Birt-Hogg-Dube locus)
-may also have renal cysts, cystadenocarcinomas, uterine leiomyomas with mutation
